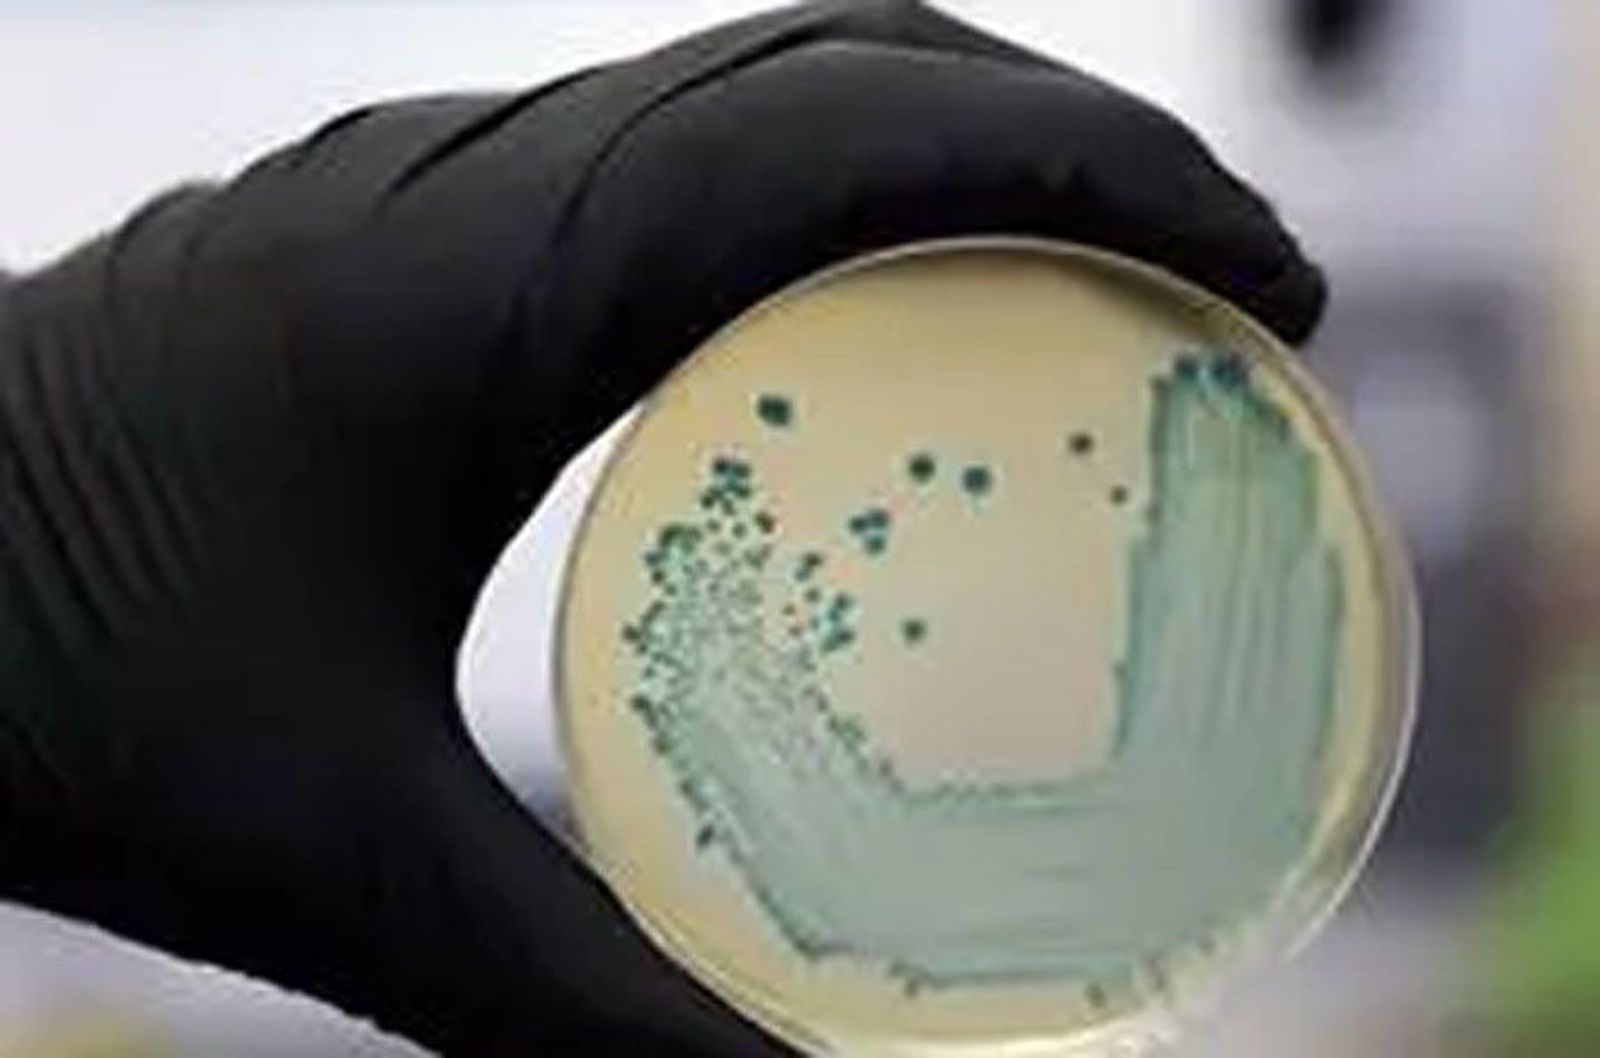
Sin título 16

Detectan la presencia de listeria en varios lotes de medallones de foie de una empresa española
Los productos han sido retirados de la venta y no hay constancia de ningún caso de listeriosis asociado al consumo de estos productos.
La Dirección de Salud Pública y Adicciones del Departamento de Salud ha sido informada por la empresa guipuzcoana Patés Zubía SL de que en los análisis internos realizados a varios lotes de medallones de foie ha detectado la presencia de 'Listeria monocytogenes'. Como medida preventiva, la empresa, en colaboración con Salud Pública, ha avisado a todos los clientes para retirar de la venta todos los productos afectados.
Según ha informado el Gobierno Vasco, los Servicios de Epidemiología no tienen constancia de ningún caso de listeriosis asociado al consumo de estos productos, pese a lo que mantienen una vigilancia específica ante cualquier sospecha de caso.
En ese sentido, ha apuntado que se están realizando las investigaciones oportunas para identificar y resolver el origen de esta contaminación microbiológica. Todo apunta a que se trata de una "contaminación cruzada puntual" que ha contaminado los medallones durante el proceso productivo.
La listeriosis tiene un período de incubación variable, de 3 a 70 días, con una mediana de 21 días. "Se suele manifestar como un cuadro febril leve, pero en personas de riesgo como mujeres embarazadas, personas inmunodeprimidas puede ser grave", ha recordado.
LOTES AFECTADOS
Los productos afectados son Medallón bloc de pato 30% trozos 70 gramos -lotes 985, 988, 1009 y 1012-; Medallón foie gras de pato mi cuit 75 gramos -lotes 986 y 1001-; Medallón bloc de foie gras de pato 70 gramos -lotes 987, 1002, 1008 y 1013-; Medallón bloc de foie gras pato pasas 75 gramos -lotes 999, 1003 y 1010-; Medallón foie de canard 70 gramos -1000, 1004, 1007 y 1011-; y Medallón de foie gras de pato mi cuit 50 gramos -lotes 353 y 354-.
El Departamento de Salud recomienda a las personas que tengan en su domicilio los citados productos se abstengan de consumirlos y los devuelvan al punto de compra y, en caso de presentar sintomatología tras consumo de estos productos, acudan a su centro de salud.
Esta información ha sido comunicada a través del Sistema Coordinado de Intercambio Rápido de Información de la Red de Alerta Nacional (SCIRI), a la Agencia Española de Seguridad Alimentaria y Nutrición (AESAN) y a las autoridades competentes de las Comunidades Autónomas donde se ha comercializado estos productos.
También te puede interesar
Lo último








